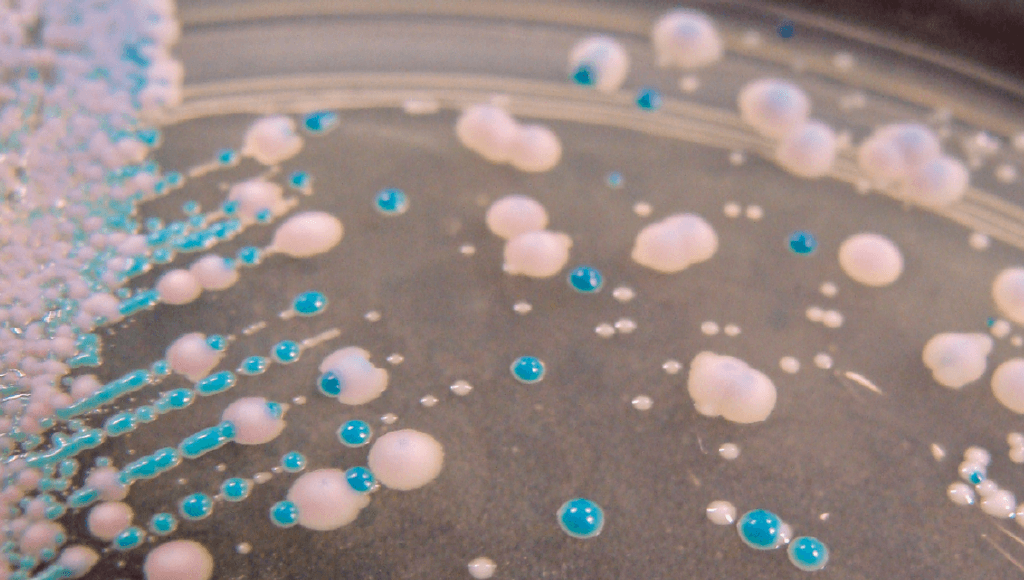

IFLScience
shared a link post in group #IFLScience

www.iflscience.com
Deadly Fungal Contagion Dubbed "Urgent Threat" By CDC Is Becoming More Infectious
It's been suggested the treatment-resistant Candida auris is getting worse with climate change.

IFLScience

shared a link post in group #IFLScience
www.iflscience.com
Deadly Fungal Contagion Dubbed "Urgent Threat" By CDC Is Becoming More Infectious
It's been suggested the treatment-resistant Candida auris is getting worse with climate change.
Comment here to discuss with all recipients or tap a user's profile image to discuss privately.
<div data-postid="qoxyrzd" [...] </div>